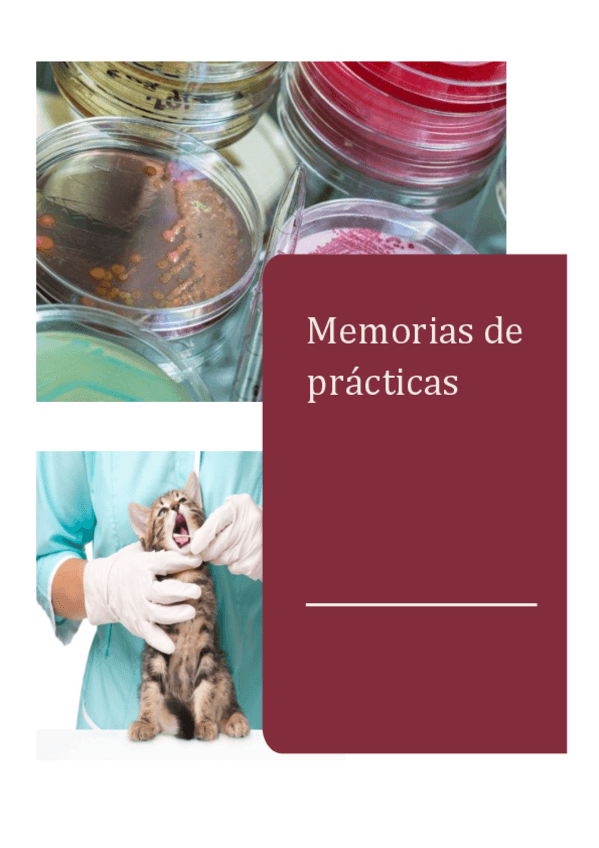

@VETEdeperol
15 Publicaciones
771 Interacciones
2 Seguidores
1 Siguiendo
Lista de publicaciones de VETEdeperol
apuntes
-
Apuntes economía 23/24
He publicado nuevos apuntes de 5º Economía de la Producción Ganadera: Apuntes economía 23/24
He publicado nuevos apuntes de 2º Microbiología e Inmunología: INFORME-DE-PRACTICAS-2-.pdf
He publicado nuevos apuntes de 2º Farmacología y Farmacia: Trabajo-antimicoticos-farma.pdf
He publicado nuevos apuntes de 1º Biología Molecular, Animal y Vegeta: Esquema-de-animal.pdf
He publicado nuevos apuntes de 1º Biología Molecular, Animal y Vegeta: Cuadros esquema biología animal para repasar (aspectos clave).pdf
He publicado nuevos apuntes de 1º Agricultura: practica-de-abonos-AGRI.pdf
He publicado nuevos apuntes de 1º Etnología, Etología y Bienestar Animal: ETOGRAMA-CONEJOS-W.pdf
He publicado nuevos apuntes de 1º Manejo de los Animales de interés veterinario: CASO-DE-TRITON.pdf
He publicado nuevos apuntes de 1º Manejo de los Animales de interés veterinario: Cuaderno-de-practicas-Manejo-wuolah.pdf